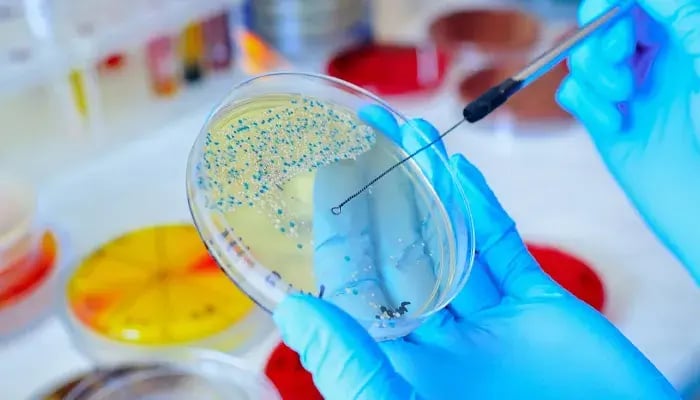
granule-healthttools-inside

Keep your systems running smoothly with tailored chemistries, automation, & proactive monitoring that prevent issues before they start.
Menu
-
Services & Solutions
BackServices & SolutionsBackWater Treatment SolutionsWater Safety & ComplianceWater Safety & Compliance SolutionsLaboratory & Analytical ServicesLaboratory & Analytical ServicesBiological Waste & Wastewater TreatmentBiological Waste & Wastewater Treatment SolutionsEquipment & AutomationEquipment & Automation SolutionsSustainable Programs
- Industries We Serve
- About
- Resource Center